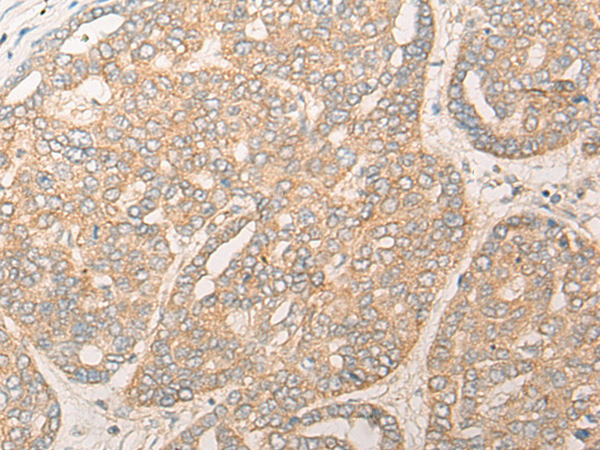

|
Background: |
This gene encodes a protein that may function as an activator of D-amino acid oxidase, which degrades the gliotransmitter D-serine, a potent activator of N-methyl-D-aspartate (NMDA) type glutamate receptors. Studies also suggest that one encoded isoform may play a role in mitochondrial function and dendritic arborization. Polymorphisms in this gene have been implicated in susceptibility to schizophrenia and bipolar affective disorder. Alternatively spliced transcript variants encoding different isoforms have been identified. |
|
Applications: |
ELISA, IHC |
|
Name of antibody: |
DAOA |
|
Immunogen: |
Full length fusion protein(153FULL) |
|
Full name: |
D-amino acid oxidase activator |
|
Synonyms: |
LG72; SG72 |
|
SwissProt: |
P59103 |
|
ELISA Recommended dilution: |
5000-10000 |
|
IHC Positive control: |
Human liver cancer;Human esophagus cancer |
|
IHC Recommended dilution: |
25-100 |

購(gòu)物車
幫助
021-54845833/15800441009
